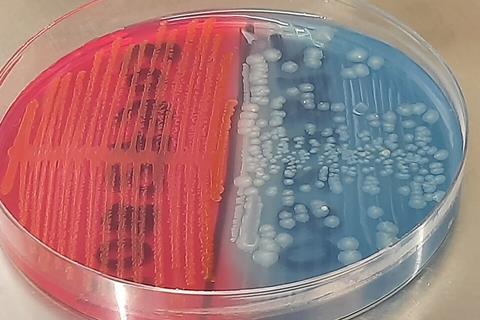
Lactose-fermenting_(LF)_strain_and_non-lactose_fermenting(NLF)_strain_of_E._coli_colony_morphology_on_CLED_medium

Researchers have pinpointed genotypic and phenotypic changes that take place when colonising bacteria in a patient’s gut invade and infect the bloodstream.
The team, supervised by Professor Adam Roberts of Liverpool School of Tropical Medicine, who sits on Applied Microbiology International’s One Health Advisory Group, aimed to determine what changes occur within bacteria in a patient’s gut that enable them to become invasive bloodstream pathogens.
The study, carried out by Dr Aakash Khanijau, a resident doctor, training in Infectious Diseases and Medical Microbiology, is published in Journal of Medical Microbiology.
“Gram-negative bloodstream infections (GNBSI) are a major cause of morbidity and mortality worldwide. Infections caused by Extended-spectrum beta-lactamase producing Escherichia coli and Klebsiella pneumoniae are of particular importance,” Dr Khanijau said.
“Invasive infections are often thought to arise from the patient’s own gastrointestinal tract but the mechanisms by which colonising bacteria transition into invasive pathogens remain poorly understood. Understanding how these organisms adapt within a patient host may improve the ability to predict, prevent, and treat these infections.”
Paired bacterial isolates
The team analysed paired bacterial isolates collected from five patients with GNBSI. For each patient the bloodstream isolate was compared to a preceding faecal isolate of the same species from that patient, using whole genome sequencing to determine if the isolates were genomically ‘linked’ and hence if the bloodstream infection was likely to have arisen from the gut in the first place. In multiple cases, they identified that the faecal and blood isolates were highly genomically related.
They then compared each of these five ‘linked’ pairs using whole-genome sequencing to identify genomic differences between faecal and blood isolates for each patient.
They looked for differences in the presence of plasmids, antimicrobial resistance genes and virulence factors, as well as mutations across the wider genome. Alongside this, they performed phenotypic testing to assess if there was a difference in antimicrobial resistance profiles and biofilm formation between faecal and blood isolates in each pair.
The findings
No pairs demonstrated an acquisition of antimicrobial resistance genes or virulence factors in the bloodstream isolate compared to the faecal isolate, Dr Khanijau said.
“However, 4/5 pairs demonstrated an increased capacity for biofilm formation in the bloodstream isolate compared to the faecal isolate, and 1/5 demonstrated increased resistance to multiple antibiotics in the bloodstream isolate compared to the faecal isolate,” he said.
“There was a range of mutations identified in each pair, whilst no single mutation was common to all pairs, but many related to the same functional COG category, and there were mutations noted within virulence genes in each pair.”
Efflux pump inhibitor
One surprising finding was that in one pair, they identified a single mutation – deletion of an efflux pump inhibitor that is likely responsible for both increasing biofilm formation and increased antimicrobial resistance. This is interesting as both virulence and AMR are potentially increased by the same mechanism, Dr Khanijau said.
“These findings improve our understanding of the pathogenesis of GNBSIs and what types of changes occur within the pathogen in the transition from colonisation to invasion,” he said.
“This demonstrates the type of information that can be gained from comparing isolates collected from the same patient at different timepoints. Identifying such changes in a larger sample of isolates could identify common mechanisms that can be targeted for identifying patients at risk of GNBSI, or targeted prevention strategies.”
This study was a collaboration between teams at Liverpool School of Tropical Medicine, University of Liverpool and Alder Hey Children’s Hospital.
Topics
- Aakash Khanijau
- Adam Roberts
- Alder Hey Children’s Hospital
- Applied Microbiology International
- Bacteria
- Biofilms
- Community
- Gram-negative bloodstream infections
- Gut Microbiome
- Infection Prevention & Control
- Infectious Disease
- Liverpool School of Tropical Medicine
- One Health
- Research News
- UK & Rest of Europe
- University of Liverpool
No comments yet